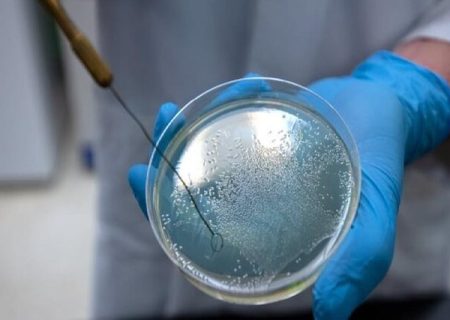
این باکتری‌ها به خون انسان تشنه هستند!

آخرین خبرها
 توکسوپلاسموز و گربهها؛ از واقعیتهای علمی تا تصورات نادرست
توکسوپلاسموز و گربهها؛ از واقعیتهای علمی تا تصورات نادرست
 بیمه دی جزو ۴ بیمه برتر کشور است
بیمه دی جزو ۴ بیمه برتر کشور است
 زنان در مرکز توجه: دستاوردها و چالشهای خدمات توانبخشی و حمایتی در ایران
زنان در مرکز توجه: دستاوردها و چالشهای خدمات توانبخشی و حمایتی در ایران
 بَکوشی اَد دَفه خِرنی بَدوشی همیشِک خِرنی
بَکوشی اَد دَفه خِرنی بَدوشی همیشِک خِرنی
 تو همچو بادِ بهاری گره گشا می باش
تو همچو بادِ بهاری گره گشا می باش
 روایت خون و باروت از لنز دوربین
روایت خون و باروت از لنز دوربین
 ساماندهی کارکنان دولت در مجمع تشخیص درحال بررسی است
ساماندهی کارکنان دولت در مجمع تشخیص درحال بررسی است
 دختران شگفتی سازان جویبار جام را بالای سر بردند
دختران شگفتی سازان جویبار جام را بالای سر بردند
اجتماعی
این باکتریها به خون انسان تشنه هستند!
پژوهشگران «دانشگاه ایالتی واشنگتن» از کشف ویژگی جدیدی در باکتریها خبر دادهاند که آنها را به خونآشام تبدیل میکند.
تجربه رشیدپور از مواجهه با ۱۲ مدیر برای گرفتن مجوز و ماجرای خبر فوتش
رضا رشیدپور که این روزها به دنبال مقدمات پخش «ساعت صفر» برای پخش از یکی از پلتفرمهاست، به گفته خودش برای دریافت مجوز این برنامه با ۱۲ مدیر فرهنگی مواجهه داشته است. این مجری اخیرا هم با حاشیهای از جنس اعلام خبر فوتش درگیر شد اما واقعیت ماجرا از این قرار بوده که این حاشیه مربوط به سکانسی از فیلم «سال گربه» است.
وام ازدواج؛ شیرینی یک قانون برای حمایت از نهاد خانواده
قانون حمایت از خانواده و جوانی جمعیت، بانک مرکزی را به پرداخت تسهیلات و وام ازدواج به منظور حمایت از جوانان برای ازدواج مکلف کرده است؛ موضوعی که هر ساله بررسی و با تصویب بودجه، ابلاغ و اجرایی میشود تا ایران را از چاله جمعیتی خارج و از مشکلات ناشی از کاهش جمعیت و نیروی کار در آینده بکاهد.
حضور اولین داور بانوی تکواندوی ایران در پارالمپیک ۲۰۲۴ پاریس
داور بین المللی تکواندو ایران برای قضاوت در بازیهای پارالمپیک به پاریس دعوت شد.
تبدیل پیکار اسرائیل – جهان اسلام به پیکار اسرائیل – ایران، راهبردی آمریکایی است
دبیر شورایعالی نوجوانان و جوانان درباره حمله صهیونیستها به ساختمان کنسولگری ایران در دمشق گفت: ایران بیشک سیلی خواهد زد اما هر اقدامی که طرفیت و پیکار میان اسرائیل - جهان اسلام را به پیکار اسرائیل - ایران محدود کند و فرو بکاهد، یک راهبرد آمریکایی است.
اتفاقی نادر در برزیل/ سلاح جدید فاطمه امینی دچار نقص شد
در مسابقات تیراندازی کسب سهمیه برزیل، سلاح جدید فاطمه امینی دچار مشکل شد.
درخشش بانوان تیرانداز/ خدمتی و چهل امیرانی فینالیست شدند
در مسابقات تیراندازی کسب سهمیه در برزیل، خدمتی و چهل امیرانی فینالیست شدند.
شکل گیری اعتمادبهنفس از دوران کودکی
یک روانشناس بالینی کودک و نوجوان گفت: مهمترین بخش زندگی افراد که از دوران کودکی شکل میگیرد داشتن اعتماد به نفس است.
دوران بزن در رو به پایان رسیده است
معاون رئیس جمهور در امور زنان و خانواده با اشاره به عملیات سپاه پاسداران در پاسخ به جنایات اخیر رژیم صهیونیستی تاکید کرد که «دوران بزن در رو به پایان رسیده است».
چرا هدف قانون جوانی جمعیت در افزایش زایمان طبیعی هنوز محقق نشده است؟
حدود ۳۰ ماه از تصویب قانون حمایت از خانواده و جوانی جمعیت و تاکید این قانون بر ترویج زایمان طبیعی با هدف بهبود نرخ باروری در کشور میگذرد اما آمارها همچنان حکایت از آن دارد که نرخ موالید به شیوه سزارین بالاتر از میانگین جهانی است.
- « برگهٔ پیشین
- 1
- …
- 11
- 12
- 13
- 14
- 15
- …
- 39
- برگهٔ بعد »